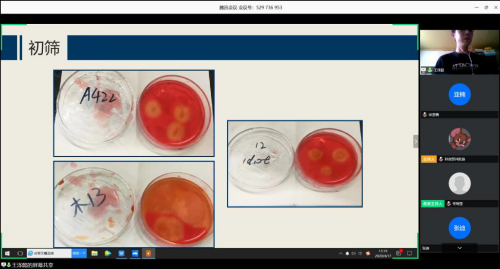

为培养大学生创新创业意识和能力,营造良好创新创业氛围,鼓励大学生积极参加创新创业类竞赛,060net永利团委按照学校《关于开展SIPT计划创新训练项目2020年中期检查工作的通知》相关要求,结合学院学生创新创业工作实际,于4月17日在线举办“2020年060net永利大学生SIPT计划项目中期检查答辩会”。学院应用生物科学系系主任李春艳教授、农业资源与环境系党支部书记马献发副教授、环境科学与工程系张迪副教授、学院团委书记孟繁美担任答辩会评委。

资环学院举办线上答辩会
参加本次答辩共计23支校级创新训练项目,课题均学术价值高并具有一定的特色性和创新性。答辩本着公平公正、盲评评选的原则,由每个项目团队进行线上的PPT展示。展示环节中,各团队对项目实施情况、项目创新点、项目取得成果、项目经费使用情况、项目存在的问题和解决办法以及参加项目的收获与体会六个方面进行汇报。

各项目团队进行项目中期答辩
各团队展示了项目前中期的发展过程和阶段性成果,展现出了资环学子科学严谨的科创态度和勇于创新的精神风貌。激励学生不断提高科技创新素质,培养科技创新能力,为大学生科技创新提供更多优秀成果。